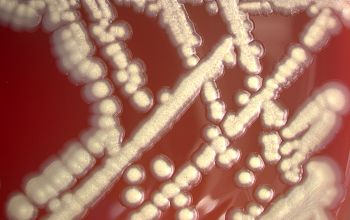

Providencia alcalifaciens
-
General information
Taxonomy
Family: Morganellaceae
P. alcalifaciens
- P. rustigianii (P. alcalifaciens biogroep 3)
P. rettgeri
P. stuartii
apathogeen P. heimbachae, P. vermicola
Natural habitats
They are ubiquitous in the environment, especially water and clinical samples, such as; urine, feces, blood, wounds and throat. Also occur in animals, mammals, birds, reptiles and insects.
Clinical significance
Patients who develop Providencia urinary tract infections often have long-standing dependence on an indwelling urinary catheter.
P. alcalifaciens, P. rustigianii, and P. heimbachae
Infections with these Providencia species are most likely to elicit gastrointestinal symptoms.
P. alcalifaciens infection is also associated with overseas travel.
-
Gram stain
Gram negative rods,
0.6-0.8 x 1.5-2.5 µm,
ranging in length from coccoid rods to long wire forms.
-
Culture characteristics
-
Facultative anaerobic
BA: colonies are large, 4mm, gray white, opaque, shiny, smooth and convex.
Brown pigmentation may occur in the center (P. rettgeri)
McConkey: growth, non lactose fermenter
BBAØ: growth
-
-
Characteristics
-
References
James Versalovic et al.(2011) Manual of Clinical Microbiology 10th Edition
Karen C. Carrol et al (2019) Manual of Clinical Microbiology, 12th Edition
https://www.tgw1916.net/Enterobacteria/Providencia.html ABIS Photo